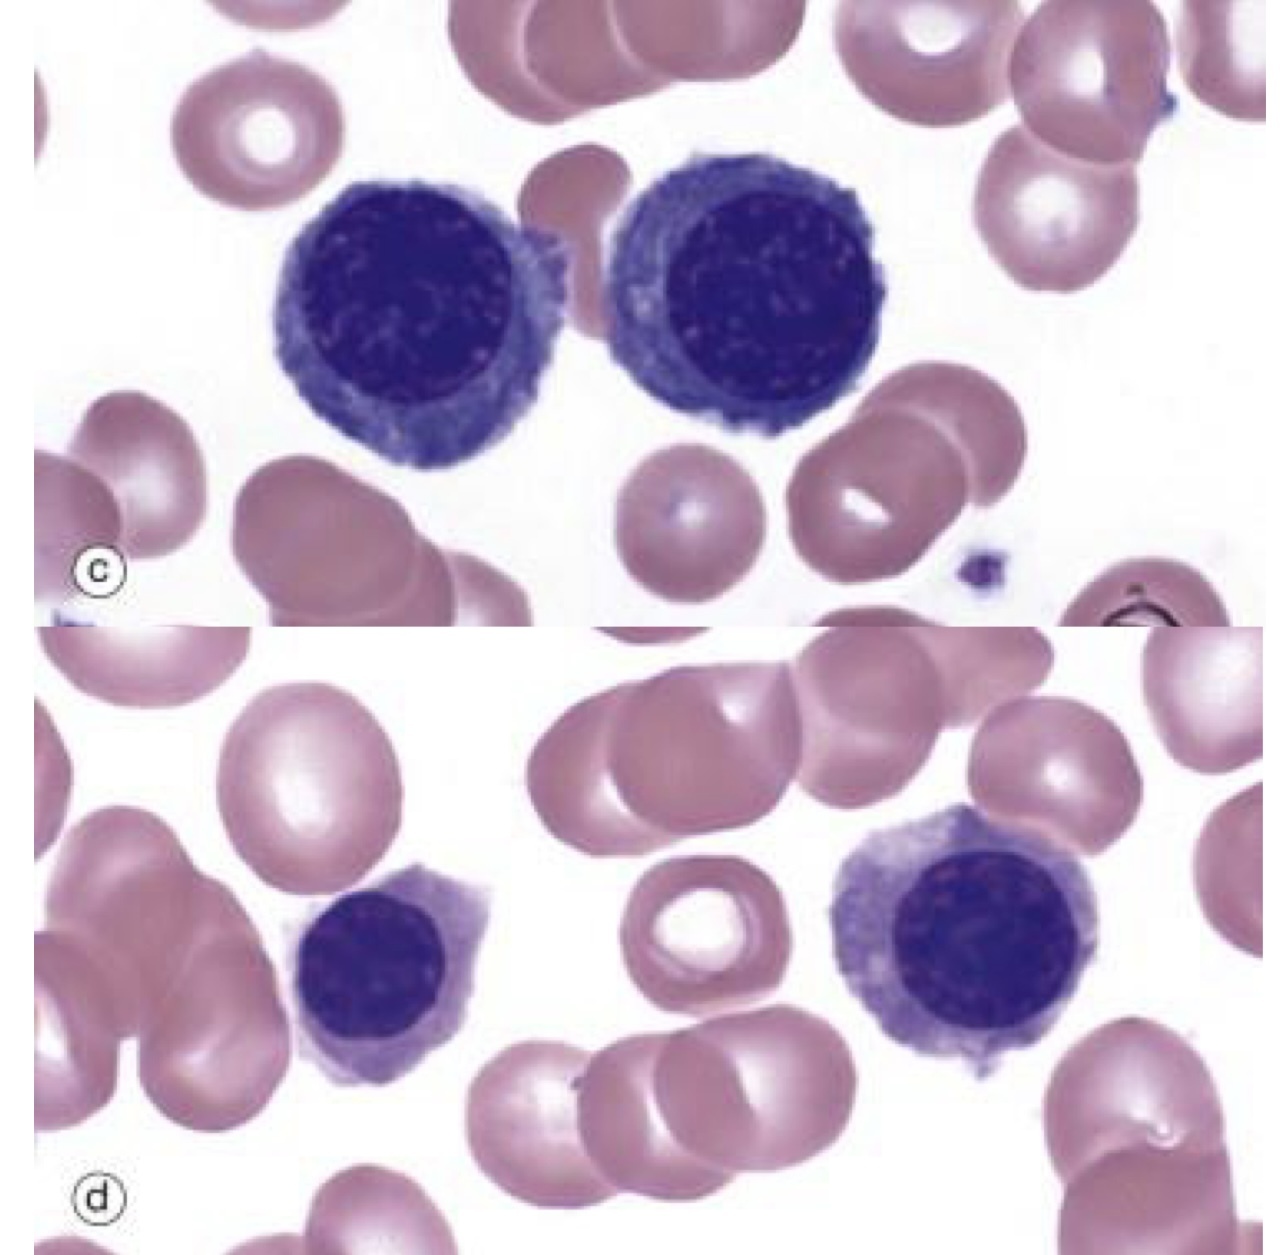
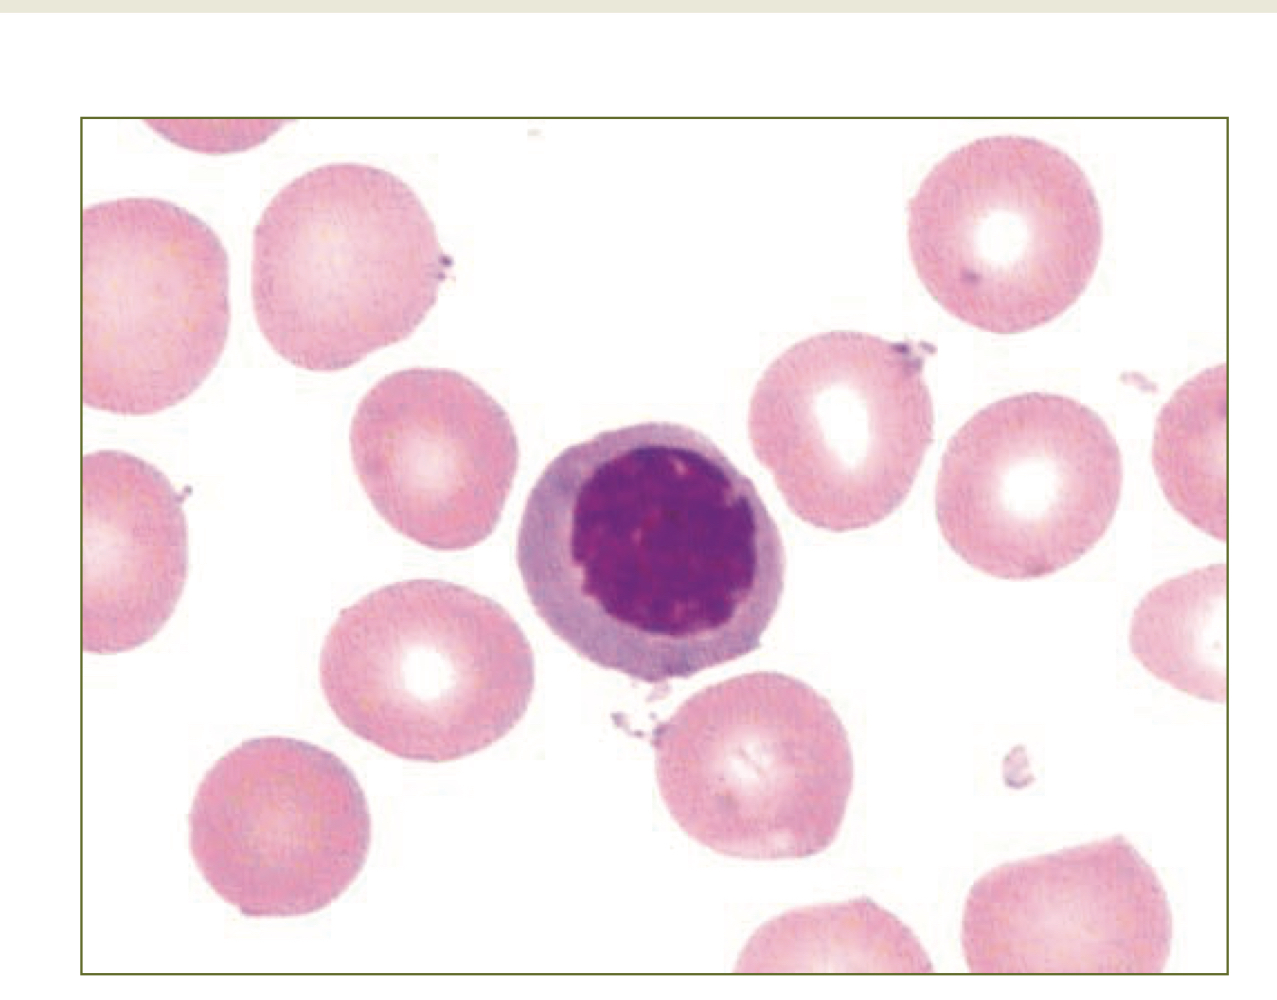
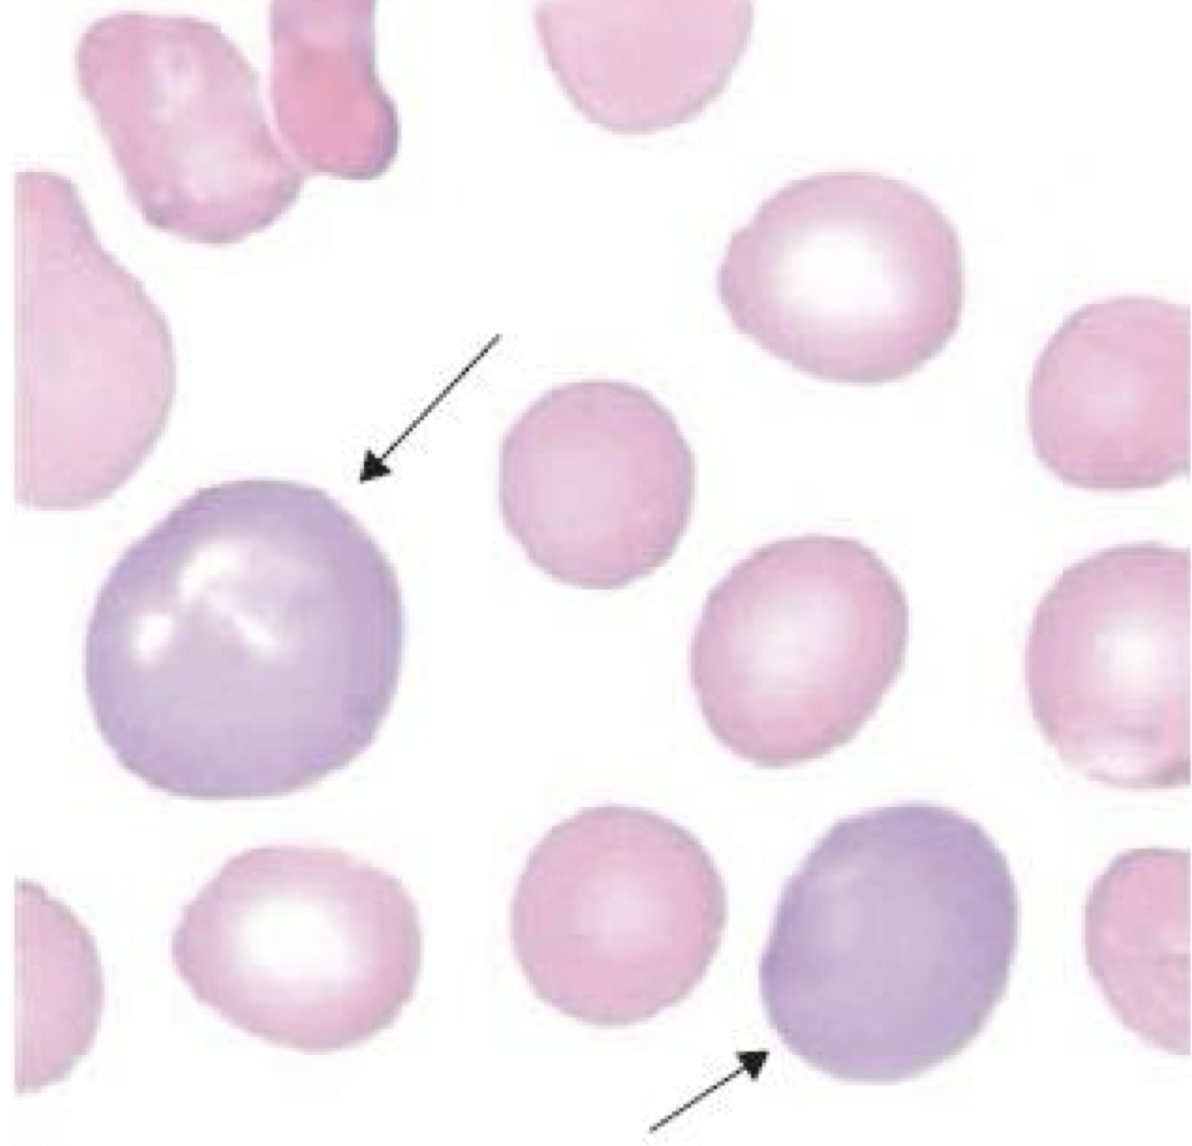
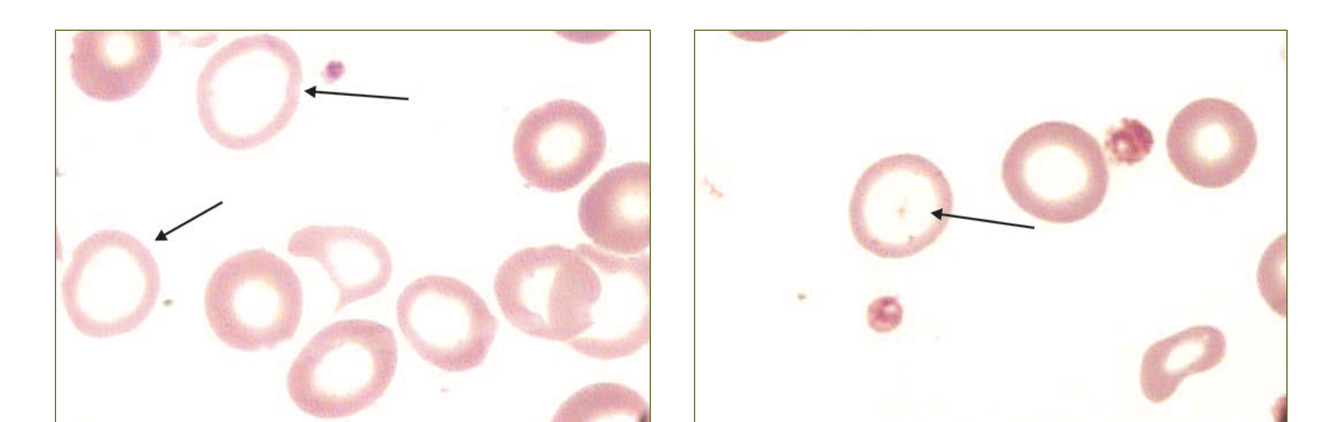
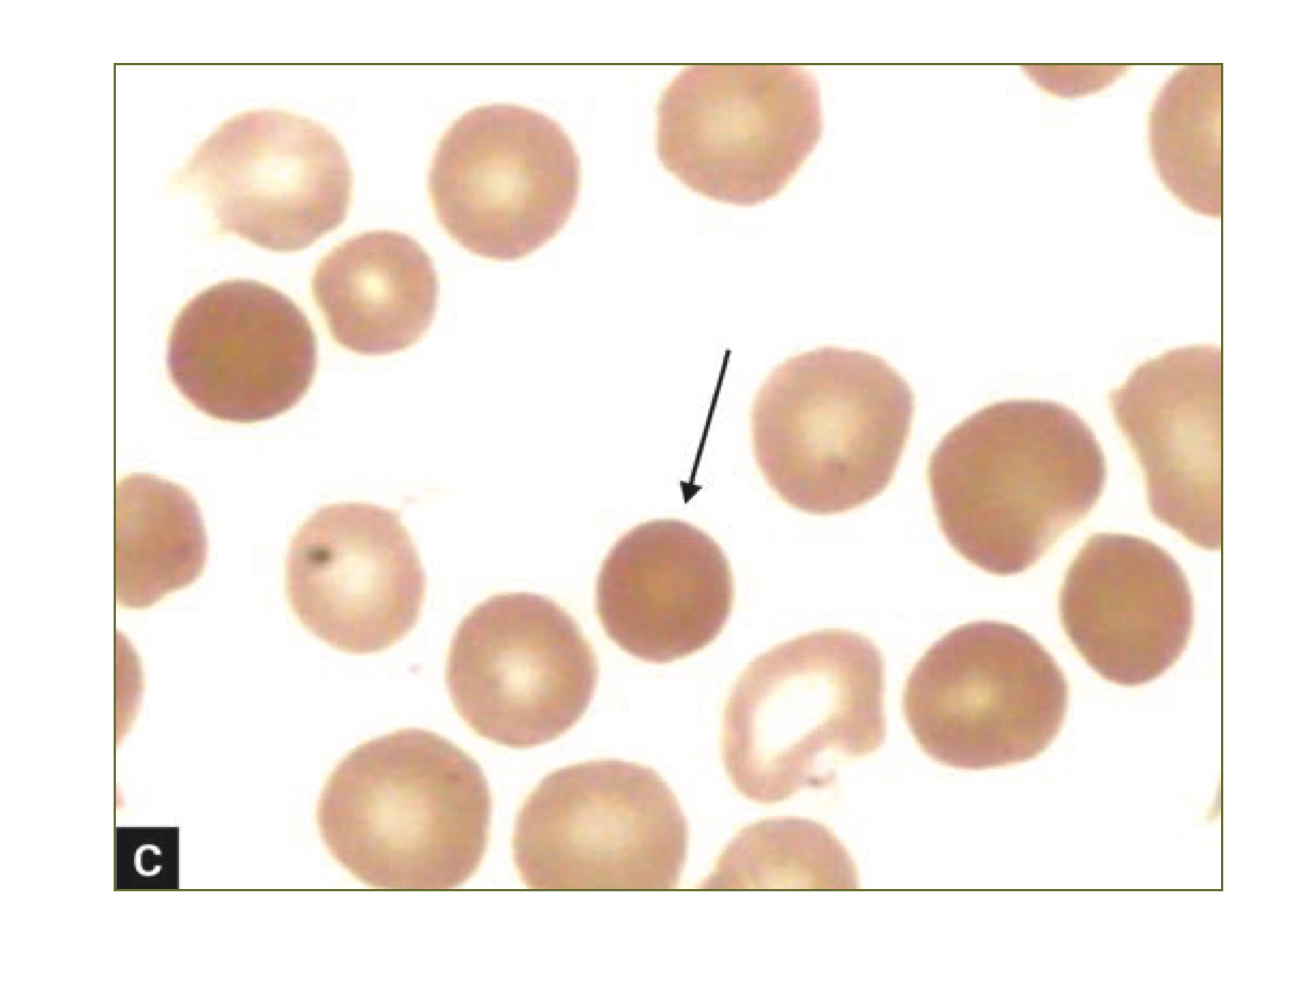
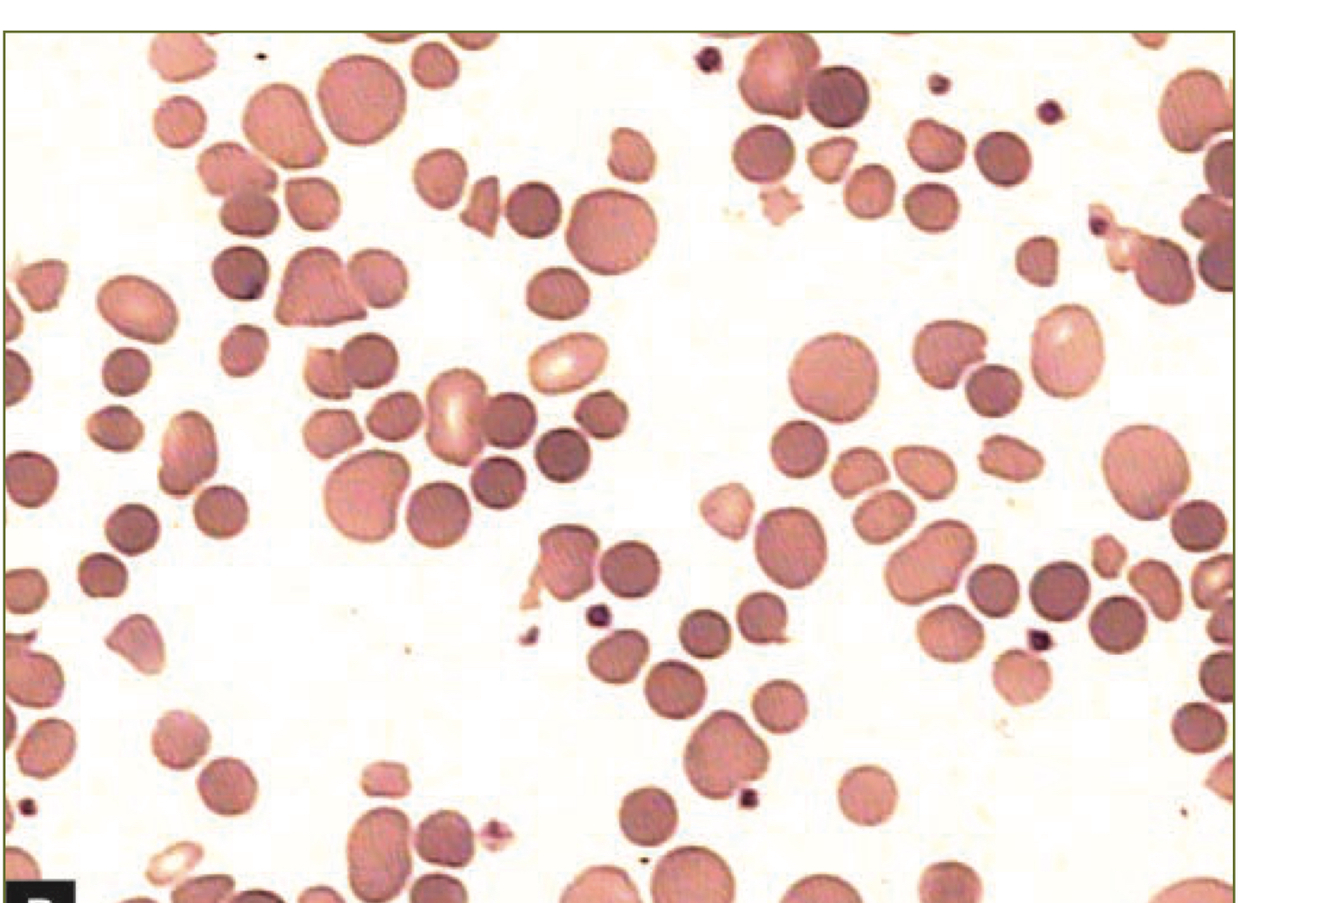
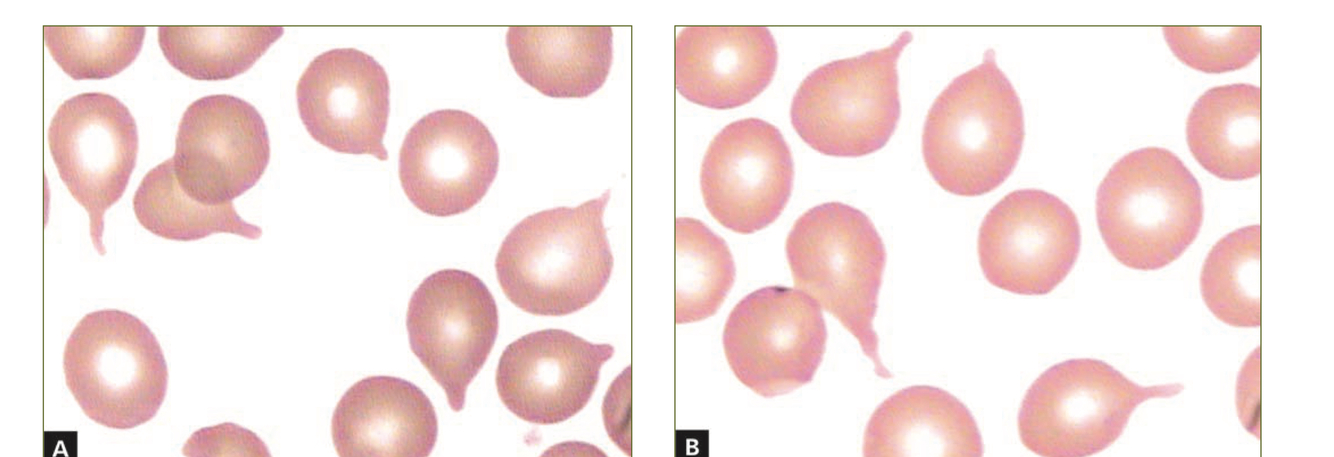
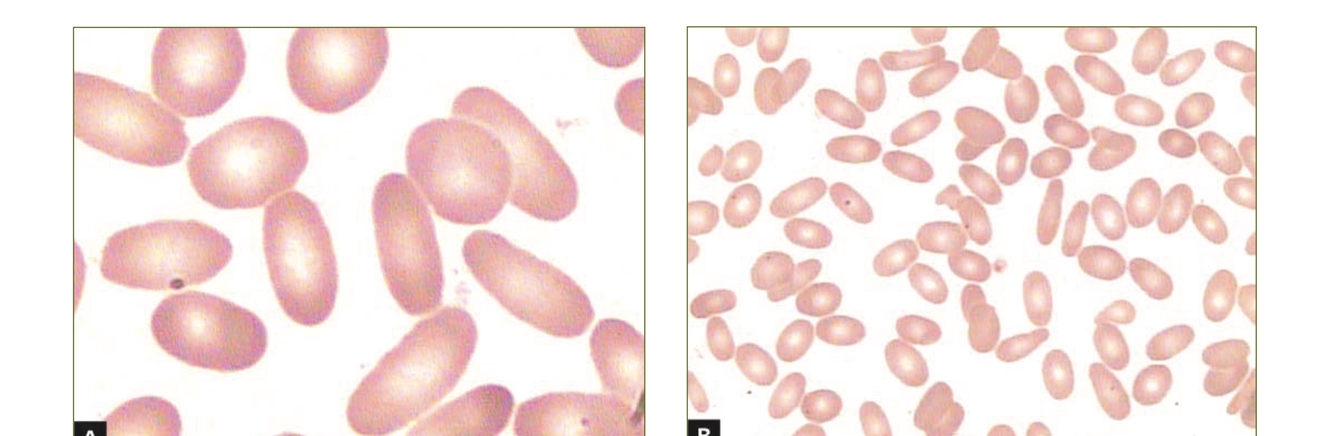
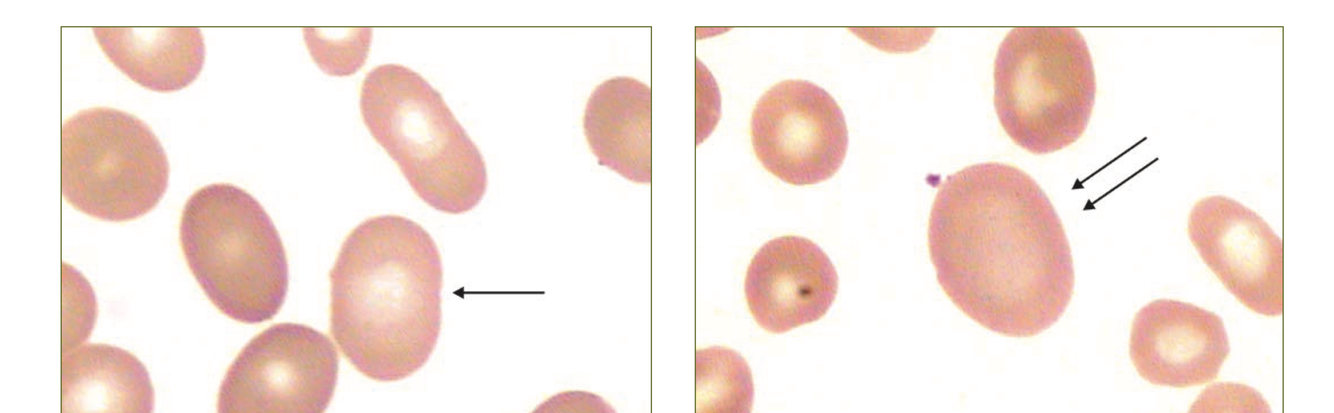
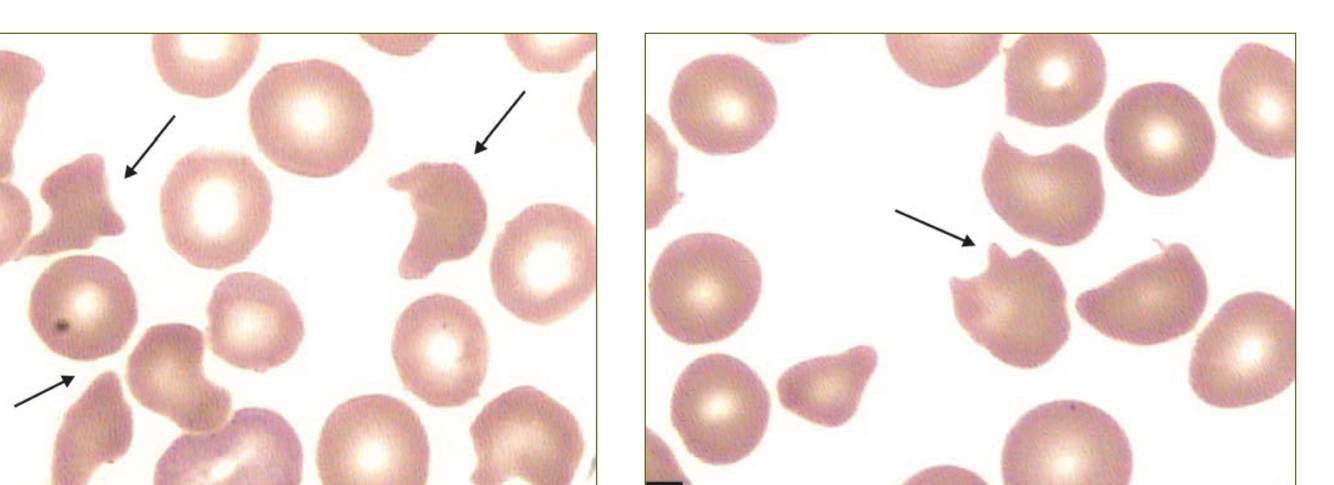
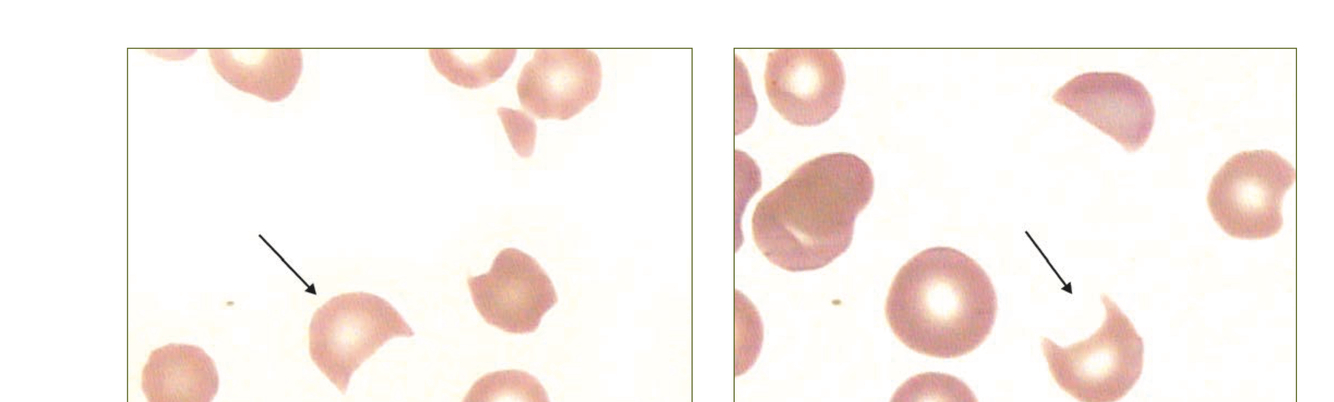
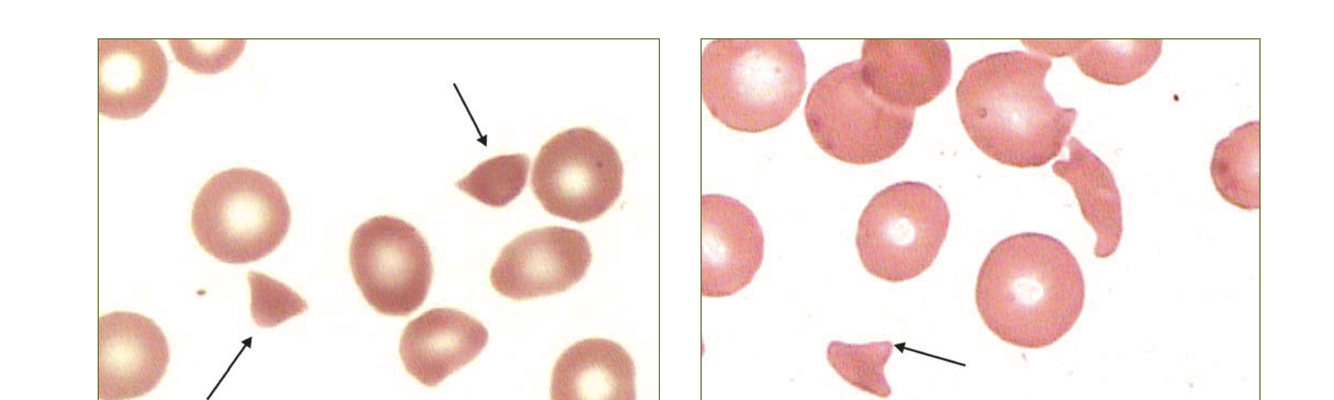
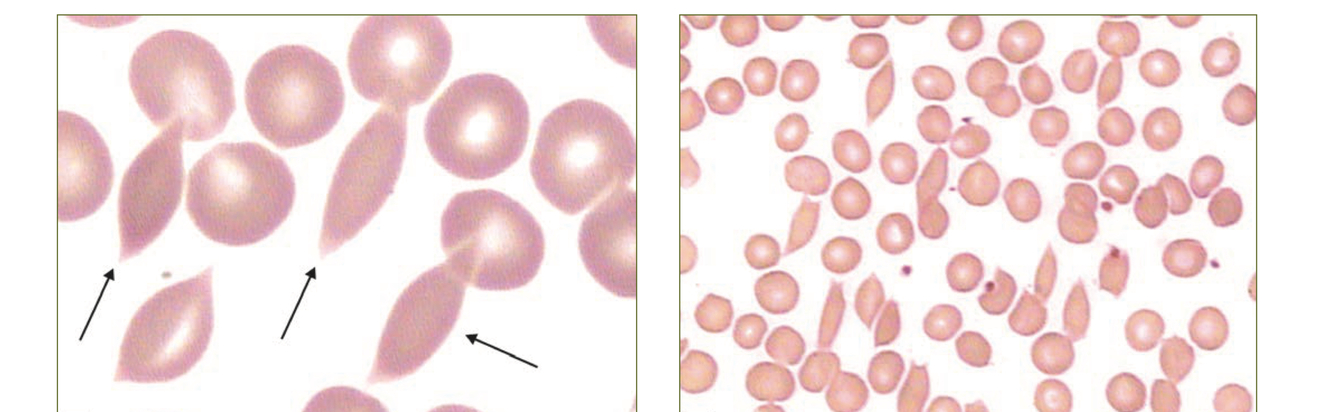
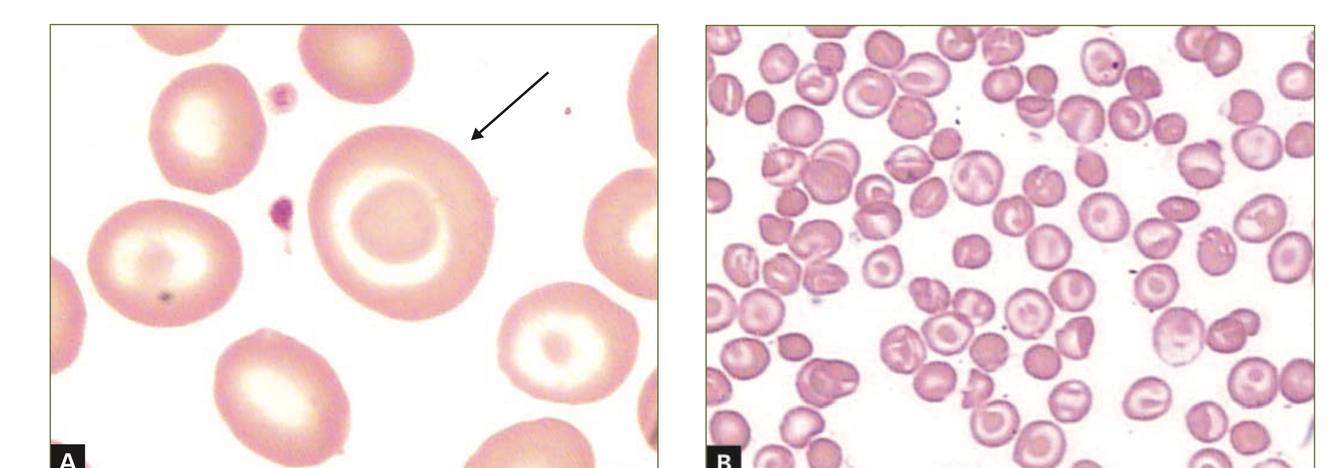
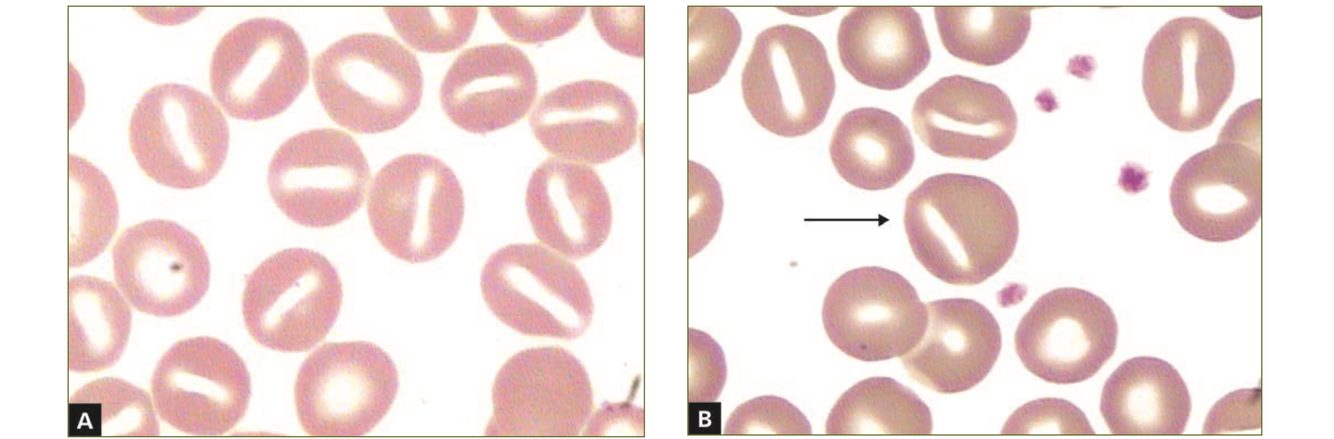
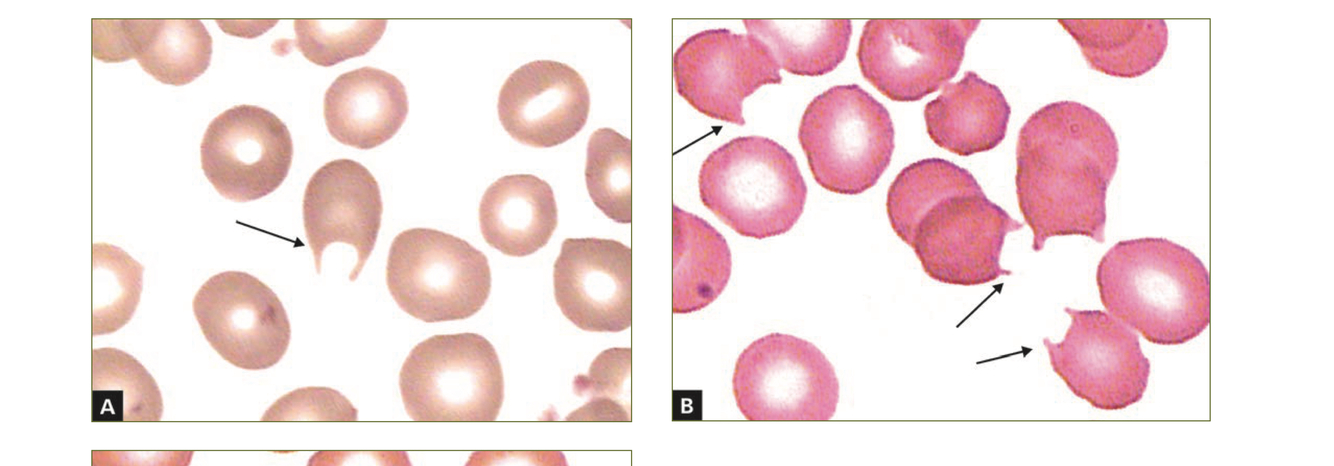
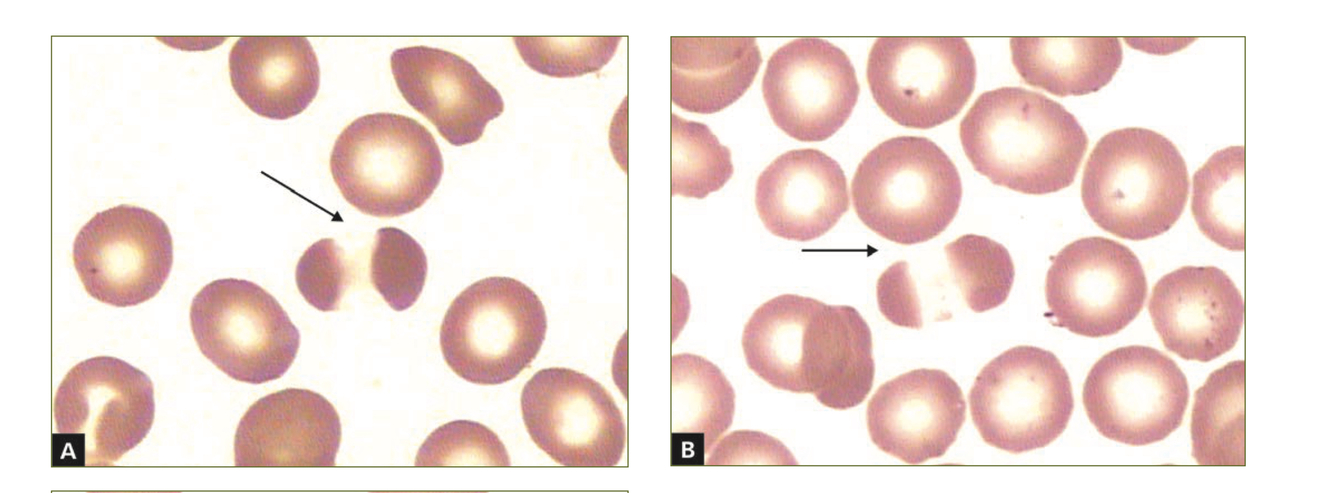
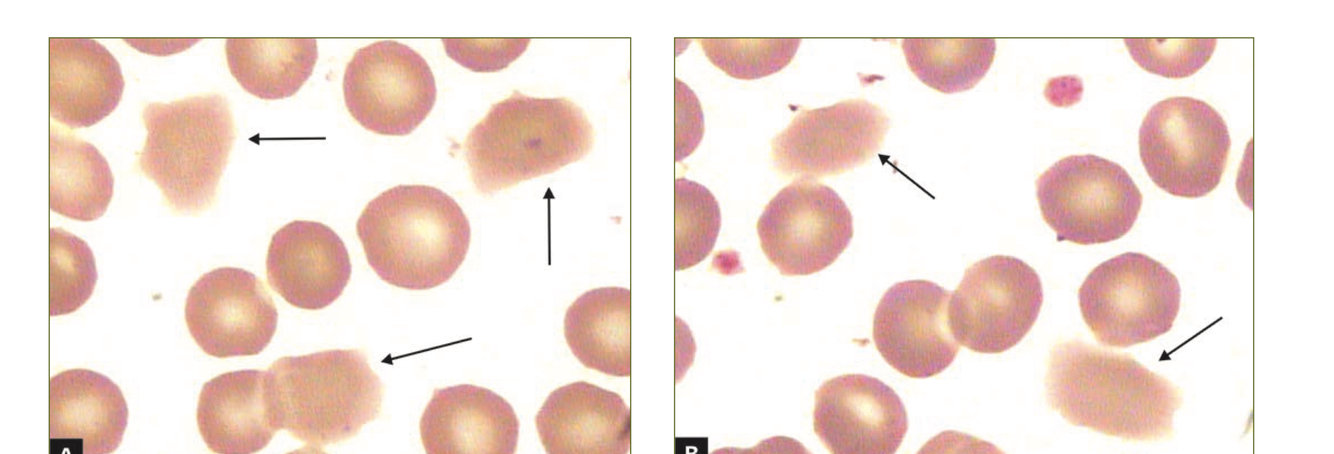
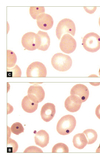
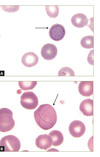
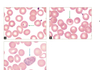
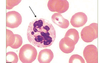

DESCREVA A CÉLULA A SEGUIR:

PROERITROBLASTO
Tamanho: 12-20 uM
Citoplasma: Intensamente basofílico com halo claro ao redor do núcleo. Pode apresentar Golgi. Pode exibir extrusões citoplasmáticas (seta)
Nucleo: Grande e arredondado, com cromatina frouxa e nucléolos
Relação N/C: 8:1
Frequencia MO: 1%

DESCREVA A CÉLULA A SEGUIR:

ERITROBLASTO BASOFÍLICO
Tamanho: 10-15 uM
Citoplasma: Mais basofílico devido ao início da hemoglobinização e alta presença de RNA
Nucleo: Circular a levemente oval, com cromatina levemente condensada e 0-1 nucléolos
Relação N/C: 6/1
Frequencia MO: 1-4%
DESCREVA A CÉLULA A SEGUIR
ERITROBLASTO POLICROMÁTICO
Tamanho: 10-12 uM
Citoplasma: Cinza-azul, como resultado da hemoglobinização, mas menos azul que o eritroblasto basofílico. Policromático pela acidofilia da hemoglobina e basofilia do RNA
Núcleo: Cromatina consensada, com nucleolos ausentes, com aspecto de tabuleiro de chadrez (“checkerbord”) ou “em salame”
Relação N/C: 4/1
Frequencia MO: 10-20%
DESCREVA A CÉLULA A SEGUIR:
ERITROBLASTO ORTOCROMÁTICO
Tamanho: 10-12 uM
Citoplasma: Coloração mais rósea que azul (alta quantidade de hemoglobina, mais semelhante a hemácia madura)
Núcleo: Circular, pequeno e denso, geralmente excêntrico, com cromatina fortemente condensada
Relação N/C: 0,5/1
Frequencia MO:: 5-10%
DESCREVA A CÉLULA A SEGUIR:

RETICULÓCITOS
Essa célula não apresenta núcleo e tem um tempo de maturação médio de 18h antes de se transformar em hemácia madura.
Mantém uma capacidade residual de sintetizar proteínas e mitocôndrias.
O reticulócitos mantem vestígios de RNA, responsável pela POLICROMASIA.
São melhores obervadas apenas na coloração com azul de cresil brilhante
DESCREVA A CÉLULA A SEGUIR
HEMÁCIA POLICROMÁTICA
A hemácia policromática pode representar reticulócitos na coloração habitual. Os reticulócitos apresentam vestígios de RNA após a expulsão do núcleo, tornando a célula mais basofílica que uma hemácia normal, mas sem nucleo para diferenciar de eritroblasto ortocromático (já expulso).
Para definir como reticulócito o ideal é a coloração com azul de cresil brilhante
DESCREVA O ACHADO A SEGUIR
HIPOCROMIA
Na hipocromia os níveis hematimétricos HCM e CHCM estão baixos, confirmando a baixa concentração de hemoglobina na célula e produzindo hemácias menos coradas que o normal.
Na hematoscopia, observa-se um aumento do halo central da hemácia. Também conhecida como “hemácia fantasma”
DESCREVA A CÉLULA A SEGUIR:
ESFERÓCITOS
É uma hemácia extremamente compata com forma esférica e geralmente pequena.
No hemograma quando há esferocitose há aumento evidente de CHCM (concentração de hemoglobina corpuscular média)
No ESP destacam-se pela coloração intensa laranja-vermelho e por não formarem rouleaux eritrocitário. Além disso, apresentam aspecto redondo bem formado
Os esferócitos podem ser formados por defeito na espectrina (esferocitose hereditária), por traumatismo físico ou quando a hemácia entra em processo de apoptose.
Causas de esferocitose:
- Esferocitose hereditária
- AHAI
- Sepse por clostridium
- Picadas de cobra
DESCREVA O ACHADO A SEGUIR
DACRIÓCITOS
Observada com maior frequência na mielofibrose. Após esplenectomia, os dacriócitos diminuem muito, indicando a existencia de hematopoese extramedular.
DESCREVA O ACHADO A SEGUIR
ELIPTÓCITO
A morfologia característica do eliptócito deve-se a um defeito na proteína de membrana espectrina. A hemácia com esse defeito perde a elasticidade normal e, quando passa em um vaso sanguíneo de pequeno calibre, deforma-se e não volta mais ao formato normal, tornando-se um eliptócito.
A existência de um grande número de eliptócitos no SP sugere uma anormalidade genética chamada de “eliptocitose hereditária” (25-90% de eliptócitos)
Eliptócitos em número < 10% são vistos em algumas talassemias, anemias megaloblásticas e anormalidades enzimáticas herdadas, além de aparecer em pacientes com hepatite C e deficiencia de ferro
É importante diferenciar o eliptócito do ovalócitos, com a ideia de que:
- Eliptócito: Eixo longo > 2x eixo curto
- Ovalócito: Eixo longo < 2x eixo curto
DESCREVA O ACHADO A SEGUIR:
OVALÓCITO / MACRO-OVALÓCITO
Alteração de membrana celular que pode ser genética ou não.
Ovalocitose hereditária: Anemia hemolítica de defeito de membrana mais comum no sudoeste asiático
Pode ser obervada em pequena quantidade raramente em algumas anemias.
É importante diferenciar o eliptócito do ovalócitos, com a ideia de que:
- Eliptócito: Eixo longo > 2x eixo curto
- Ovalócito: Eixo longo < 2x eixo curto
O macro-ovalócito é uma hemácia observada frequentemente no SP de pacientes com anemia megaloblástica. Em geral é uma hemácia policromática, com tom azul-acinzentado. Aprtesenta tamanho aumentado e policromática pela deficiencia de acido folico e B12 que são essenciais para a hematopoiese normal.
DESCREVA O ACHADO A SEGUIR
ESQUIZÓCITOS
- Hemácia com morfologia variável e irregular, geralmente com metade do tamanho de uma hemácia comum
- Pode ser interpretada com o “bite cells”no contexto de deficiencia de G6PD pela retirada no baço da parte da hemácia que contem o corpusculo de Heinz
- Pode acontecer também em anemias hemolíticas por ação mecânica (MAT)
DESCREVA O ACHADO A SEGUIR
ESQUIZÓCITOS EM CAPACETE
- Também conhecida como helmet cell
- É um tipo de esquizócito mais relacionado com o traumatismo mecânico (fragmentação física) com coágulos de fibrina intravascular
- Sugere mais MAT
DESCREVA O ACHADO A SEGUIR:
FRAGMENTOS DE HEMÁCIAS
- Surgem da ação mecânica direta sobre sua estrutura
- Acontece quando a hemácia passa por um capilar sanguíneo com fibrina aderida no endotélio ou mediante contato com uma superfície anormal como uma valva cardíaca
- Também são comuns na destruição mecânica pela rede de fibrina em MAT
DESCREVA O ACHADO A SEGUIR:

ACANTÓCITOS
- Hemácia que apresenta projeções citoplasmáticas denominadas espículas, dristribuidas irregularmente ao redor da célula
- Apresenta espículas de tamanhos variáveis e em menor quantidade que a hemácia crenada
Podem ser encontrados em:
- Cirroses
- Anemias hemolíticas associadas ao fígado
- Heparina
- Hepatites
- Pós esplenectomia
- Abetalipoproteinemia
DESCREVA O ACHADO A SEGUIR

DREPANÓCITO
- Hemácia em foice característico de anemia falciforme
- Hemoglobina S se polimeriza e leva ao processo de falcização da hemácia. Esse processo depente da quantidade de O2, temperatura e concentração intracelular de HbS
DESCREVA O ACHADO A SEGUIR
HEMÁCIA FUSIFORME
- Alguns pacientes portadores do genótipo Hb AS apresentam no ESP células com morfologia alongada e extremidades afiadas denominadas hemácias fusiformes
- Ocorre pelo rompimento do processo de falcização. Como a falcização é incompleta a célula fica com formato alongado
- Geralmente esssa hemácia se forma apenas na formação da lâmina quando há falta de O2
DESCREVA O ACHADO A SEGUIR
HEMÁCIAS EM ALVO
- Tambem chamado de codócito
- Apresenta área central redonda com coloração norma. Em volta existe uma área branca, sem coloração e depois um anel normocrômico periférico, formando uma biconcavidade
- Ocorre por causa da célula ter mais membrana celular com relação ao volume intraeritrocitário. Esse efeito está relacionado com má distribuição de hemoglobina na hemácia
- Presente em grande quantidade na hemoglobinopatia C ou associação de hemoglobinopatia com outras (SC, talassemias, doenças hepaticas…)
- Ocorre frequentemente como artefato de confecção inadequada do esfregaço
DESCREVA O ACHADO DA IMAGEM

EQUINÓCITO / HEMÁCIA CRENADA
- Células com projeções espiculares regulares e uniformes sobre toda a membrana celular
- Perde a forma discoide e sua deformabilidade, se tornando mais rígida e facilitando sua lise no baço
Principais causas:
- Baixa concentração de ácido graxo
- Tratamento com heparina
- Uremia
- Hepatopatias
- Insuficiencia renal
- SHU
- Câncer
- Úlcera peptica
- Deficiencia de piruvato quinase
DESCREVA O ACHADO DA IMAGEM
ESTOMATÓCITO
- Ocorre quando a pequena área clara no centro da hemácia (biconcavidade) é modificada por uma faixa clara que cruza toda a célula
- Ocorre devido ao aumento de sódio e diminuição de potássio intracelular
Possíveis causas:
- Alcoolismo agudo
- Cirrose hepática
- Estomatocitose hereditária
- Talassemias menores
- Intoxicação por chumbo
- Mononucleose
Muito comum aparecer em áreas isoladas da lamina como artefato da confecção
DESCREVA O ACHADO A SEGUIR

HEMÁCIA EM BOLHA
- Ocorre formação de bolhas no interior da célula
- As bolhas originam-se da fusão da membrana celular interna da célula, deixando uma área desprovida de hemoglobina
- Quando a bolha é rompida ou fagocitada pelo baço, originam-se outras hemácias como queratócitos ou esquizócitos
- Também pode ser vista em anemias, microangiopatias, anemia falciforme, TEP
DESCREVA OS ACHADOS A SEGUIR:
QUERATÓCITOS
- Também conhecido como bite cells
- Hemácias com um ou mais pares de espículas
- Se originam de uma ou mais mordidas de macrófagos esplenicos ou por dano celular traumático. Também pode surgir pela ruptura de uma hemácia em bolha
Principais causas:
- Deficiencia de G6PD
- MAT
- Nefropatias pós transplante
DESCREVA OS ACHADOS A SEGUIR
PICNÓCITOS
- Também conhecido como dagmático
- Forma de hemácia que tem a hemoglobina retraída para as laterais da célula, deixando a área central da célula vazia sem hemoglobina
- Geralmente é uma célula alongada
- Ocorrencia rara
Principais causas:
- Deficiencia G6PD
- Anemia hemolítica intravascular
- MAT
Deficiencia hereditária de lipoproteínas
DESCREVA OS ACHADOS A SEGUIR
HEMÁCIAS BORRADAS
- Células queperderam definição do contorno da membrana celular, ficando com aparencia borrada e deformada
- Associada a altas taxas de lipídios (hiperlipidemia), mais precisamente com triglicérides > 1000.
- O excesso de lipídeos prejudica o equilíbrio da composição de membrana lipoproteica da hemácia
- Importante diferenciar de artefatos de formação da lamina pela dosagem de perfil lipídico